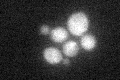
YDR435C
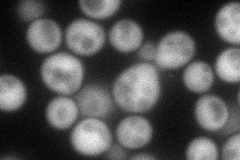
YDR435C
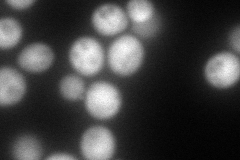
YDR435C
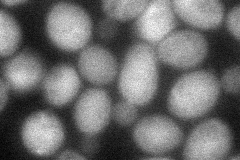
YDR435C

View description
Carboxyl methyltransferase, methylates the C terminus of the protein phosphatase 2A catalytic subunit (Pph21p or Pph22p), which is important for complex formation with regulatory subunits
Localization:
Intensity:
Fold change:
Significance:
-
C’ GFP library in SD
cytosol22.05 -
N' NOP1pr-GFP in SD
cytosol98.1054 -
N' TEF2pr-mCherry in SD
cytosol176.746 -
N' NATIVEpr-GFP in SD

below threshold24.0271 -
N' TEF2pr-VC and Cyto-VN in SD
cytosol51.7411 -
C’ GFP library in SD+DTT

cytosol20.190.91No -
C’ GFP library in SD+H2O2

cytosol20.870.94No -
C’ GFP library in Starvation Media

cytosol29.321.32No -
C’ GFP library on the background of Pup2-DaMP

cytosol -
C’ GFP library on the background of CCT mutant

cytosol24.26721.10012No
